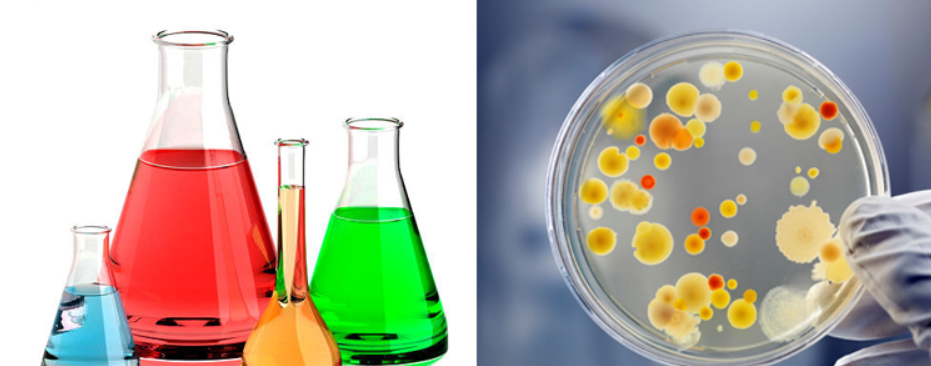

Sự thật về vi sinh ăn mỡ EcoClean EcoBlock: Có thực sự thần thánh như lời đồn?
Trong những năm gần đây, cụm từ “vi sinh ăn mỡ” xuất hiện ngày càng nhiều trong các giải pháp xử lý bể mỡ, bẫy mỡ và hệ thống thoát nước cho nhà hàng, quán ăn và hộ gia đình. Nhiều quảng cáo mô tả vi sinh như một giải pháp “thần kỳ”: chỉ cần thả vào bể mỡ, dầu mỡ sẽ tự động biến mất, không cần hóa chất, không cần hút bể định kỳ.
Tuy nhiên, điều này cũng khiến không ít người hoài nghi.
👉 Vi sinh là những sinh vật cực nhỏ, trong khi dầu mỡ lại là chất bám dính, tích tụ lâu ngày và rất khó xử lý.
👉 Liệu “vi sinh ăn mỡ” có thực sự hoạt động như cách mà quảng cáo vẫn nói, hay chỉ là một cách gọi mang tính marketing?
Bài viết này của Ecodeals sẽ phân tích bản chất khoa học của vi sinh ăn mỡ, làm rõ cơ chế hoạt động thực tế, cũng như đánh giá mức độ hiệu quả của các sản phẩm phổ biến trên thị trường như EcoClean EcoBlock.
1. Vi Sinh Ăn Mỡ là gì? - Không phải “thần thánh”, nhưng có khoa học

“Vi sinh ăn mỡ” là chế phẩm sinh học chứa quần thể vi khuẩn và enzyme có khả năng phân hủy chất béo, dầu mỡ và hữu cơ trong nước thải. Chúng không ăn mỡ như người ăn uống, mà giải phóng enzyme lipase, protease… để phá vỡ phân tử mỡ thành các chất đơn giản hơn như CO₂ và nước thông qua phản ứng sinh học.
Nói cách khác, vi sinh không “ăn mỡ” theo nghĩa đen, mà phân hủy mỡ thông qua phản ứng sinh học tự nhiên.
👉 Đây là công nghệ đã được nghiên cứu trong môi trường xử lý nước thải và bẫy mỡ công nghiệp, được dùng rộng rãi trong xử lý nước thải hầm tự hoại, bể tách mỡ, bể bẫy grease trap…
2. Câu chuyện ra đời của vi sinh xử lý mỡ EcoClean EcoBlock

Câu chuyện bắt đầu từ những "cơn ác mộng" tại các bếp công nghiệp quy mô lớn, nơi dầu mỡ tích tụ lâu ngày đóng bánh cứng như đá, gây tắc nghẽn và bốc mùi nồng nặc. Việc phụ thuộc vào hóa chất thông cống tuy cho hiệu quả nhanh, nhưng lại tiềm ẩn rủi ro ăn mòn đường ống và ô nhiễm môi trường nước.
Từ thực tế đó, các chuyên gia môi trường và công nghệ sinh học đã đặt ra một câu hỏi đơn giản:Liệu có thể xử lý dầu mỡ bằng chính cơ chế tự nhiên, thay vì dùng hóa chất mạnh?
EcoClean EcoBlock - vi sinh vật phân hủy chất hữu cơ ra đời từ chính hướng tiếp cận đó. Đây là những chủng vi khuẩn đã tồn tại sẵn trong tự nhiên và được ứng dụng rộng rãi trong xử lý nước thải. Khi được tuyển chọn đúng chủng và nuôi cấy ở mật độ phù hợp, các vi sinh này có khả năng tiết enzyme để phân hủy dầu mỡ một cách an toàn và bền vững.
3. Bền vững lâu dài - Thay thế xử lý hóa chất tạm thời
Khác với các giải pháp xử lý tức thời, vi sinh ăn mỡ Ecoclean:
-
Hoạt động liên tục sau khi đưa vào hệ thống
-
Phân hủy dầu mỡ phát sinh hằng ngày
-
Hạn chế tình trạng tái tích tụ gây tắc nghẽn
-
Phù hợp cho các hệ thống vận hành thường xuyên
Nhờ cơ chế này, mỡ không chỉ được xử lý tại thời điểm sử dụng mà còn hạn chế tích tụ trở lại, giúp hệ thống thông thoáng trong thời gian dài.
4. Phân hủy từ gốc - Xử lý dầu mỡ tận nguyên nhân

Thông qua enzyme, vi sinh phá vỡ cấu trúc dầu mỡ thành các hợp chất đơn giản hơn, từ đó làm giảm đáng kể khả năng bám dính của mỡ lên thành ống và bể mỡ:
-
Xử lý tận gốc nguyên nhân gây tắc nghẽn
-
Giảm mảng bám tích tụ lâu ngày trong hệ thống
-
Làm sạch hệ thống từ bên trong, không chỉ bề mặt
Khi dầu mỡ bị cắt nhỏ và chuyển hóa dần, khả năng bám dính vào thành ống giảm đáng kể. Nhờ đó, hệ thống được cải thiện từ bên trong thay vì chỉ “thông tạm” bề mặt.
5. Không ăn mòn đường ống - Mạnh với mỡ, nhẹ với đường ống

Bạn có biết rằng chính các hoạt chất mạnh trong hóa chất thông tắc lại là nguyên nhân âm thầm làm hỏng hệ thống thoát nước?
Một trong những hạn chế lớn của hóa chất thông tắc là tính ăn mòn cao. Việc sử dụng lặp lại trong thời gian dài có thể làm suy yếu bề mặt đường ống và ảnh hưởng trực tiếp đến bể mỡ, đặc biệt với những hệ thống đã cũ.
Trong khi đó, vi sinh ăn mỡ hoạt động hoàn toàn tự nhiên, không tạo ra phản ứng hóa học mạnh và không gây hư hại vật liệu. Vi sinh xử lý dầu mỡ một cách nhẹ nhàng nhưng liên tục, giúp hệ thống duy trì trạng thái ổn định lâu dài.
6. Thân thiện và an toàn – Xử lý hiệu quả mà vẫn “xanh”

Trong bối cảnh các tiêu chuẩn môi trường ngày càng được siết chặt, vi sinh ăn mỡ trở thành giải pháp được ưu tiên nhờ tính an toàn sinh học:
-
Không phát sinh hóa chất độc hại sau xử lý
-
Ít ảnh hưởng đến hệ vi sinh tự nhiên trong môi trường
-
Phù hợp với xu hướng xử lý xanh và bền vững
-
Giảm nguy cơ ô nhiễm nguồn nước xung quanh
Vi sinh ăn mỡ không đơn thuần là một giải pháp xử lý, mà là bước chuyển mình từ tư duy “giải quyết sự cố” sang xử lý xanh, an toàn và bền vững cho tương lai.
7. Sự thật: Có thực sự “thần thánh” như lời đồn?
✔ Có hiệu quả thật - nhưng không phải ngay tức thì:
-
Vi sinh cần thời gian để phát triển và phân hủy mỡ (có thể nhiều ngày đến vài tuần), không tức thì như hóa chất mạnh.
-
Hiệu quả phụ thuộc vào điều kiện vận hành: pH, nhiệt độ, lưu lượng nước, lượng mỡ... nên không thể cam kết 100% trong mọi trường hợp.
👉 Ví dụ từ nghiên cứu thực nghiệm: một số chủng vi sinh có thể loại bỏ 60–65% chất béo trong điều kiện thử nghiệm.
Như vậy, vi sinh giúp giảm mỡ đáng kể, nhưng không biến mất mọi mỡ trong chốc lát như quảng cáo thường nói.
8. Vì sao nên chọn giải pháp vi sinh ăn mỡ Ecoclean ?
- ✔ Thân thiện môi trường – không hóa chất độc hại
- ✔ Duy trì hoạt động bền vững của hệ thống thoát nước
- ✔ Giảm tắc nghẽn và chi phí bảo trì định kỳ
- ✔ Giảm mùi hôi và tăng hiệu quả xử lý tổng thể
Mỗi lần sử dụng là một cách bạn chọn giải pháp an toàn – cho đường ống, cho hệ sinh thái, và cho môi trường sống xung quanh.
| Tham khảo sản phẩm: Tại đây !
9. Kết luận: “Không thần thánh, nhưng có giá trị thực”
👉 Vi sinh ăn mỡ không phải phép màu, nhưng là giải pháp sinh học bền vững, an toàn và hiệu quả để xử lý mỡ lâu dài nếu sử dụng đúng cách và đúng sản phẩm.
Quan trọng hơn, đây là hướng tiếp cận hài hòa giữa hiệu quả kỹ thuật và trách nhiệm môi trường.
🌱Gạt đi nỗi lo về những lần tắc nghẽn hay mùi hôi khó chịu, hãy để EcoBlock giúp bạn duy trì hệ thống thoát nước luôn thông thoáng, sạch sẽ và vận hành trơn tru mỗi ngày.








